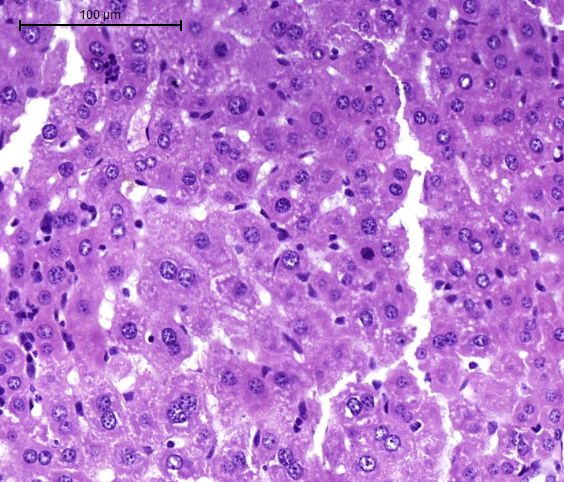
索莱宝全信息数字化切片扫描服务,为您的实验保驾护航!

14 年
手机商铺
技术资料/正文
502 人阅读发布时间:2020-03-17 10:19
不知大家在做免疫组化,荧光组化等病理实验时,遇到哪些烦恼和纠结?会不会在辛辛苦苦做完实验,最后关键的切片拍照时刻,也有很纠结的情况。有时即使显微镜的最低倍数也不能呈现整体,只好转战体视镜,体视镜拍完发现,有小细节还是没拍好还要再回去找显微镜。那么,今天和大家聊聊打开新世界大门的一台仪器:3DHISTECH全信息数字化病理切片扫描系统。

3DHISTECH是由Three-dimensional Histological Technologies三维组织学技术拼写而来,可以将整个载玻片全信息、全方位、快速扫描。其中一款仪器型号为P250 FLASH,P代表Panoramic,250代表单次250张切片的高通量,FLASH顾名思义就是闪电。这台仪器是国际上扫描速度最快的病理切片扫描仪,连续三届获得国际扫描仪大赛“图像质量”金奖,并连续两届荣获国际扫描仪大赛“扫描速度”金奖。

话不多说,结果说话

胚鼠Von Kossa+HE染色
(一个图片文件从0.5x到40x,完美放大缩小)
如果只有全景就觉得打开了新世界的大门,也未免太低估这台仪器了。这款机器有一款必杀技:多层融合扫描。相信大家都有过这种经历,类似下图这种切片,是不是让人很崩溃?普通显微镜,哪怕是共聚焦也对这种薄厚不均的切片束手无策。但是,有了多层融合扫描(景深扩展扫描)就看得到了曙光。通过手动设置机器逐层扫描,可以达到30层,精度0.2微米,每一层清楚的图像区域融合为一层,大大提高了图片的质量。
如果您的实验一直停滞不前,您的文章图片需要优化?疫情期间,复工被再次延期,但是对于科研工作者来说,延工不能延科研,不能延毕业。所有的问题和难题可以交给索莱宝最专业的技术服务团队和最先进的仪器分析平台来解决。3DHISTECH全信息数字化病理切片扫描系统(明场、荧光均可扫描,9荧光通道),为您的实验保驾护航!


